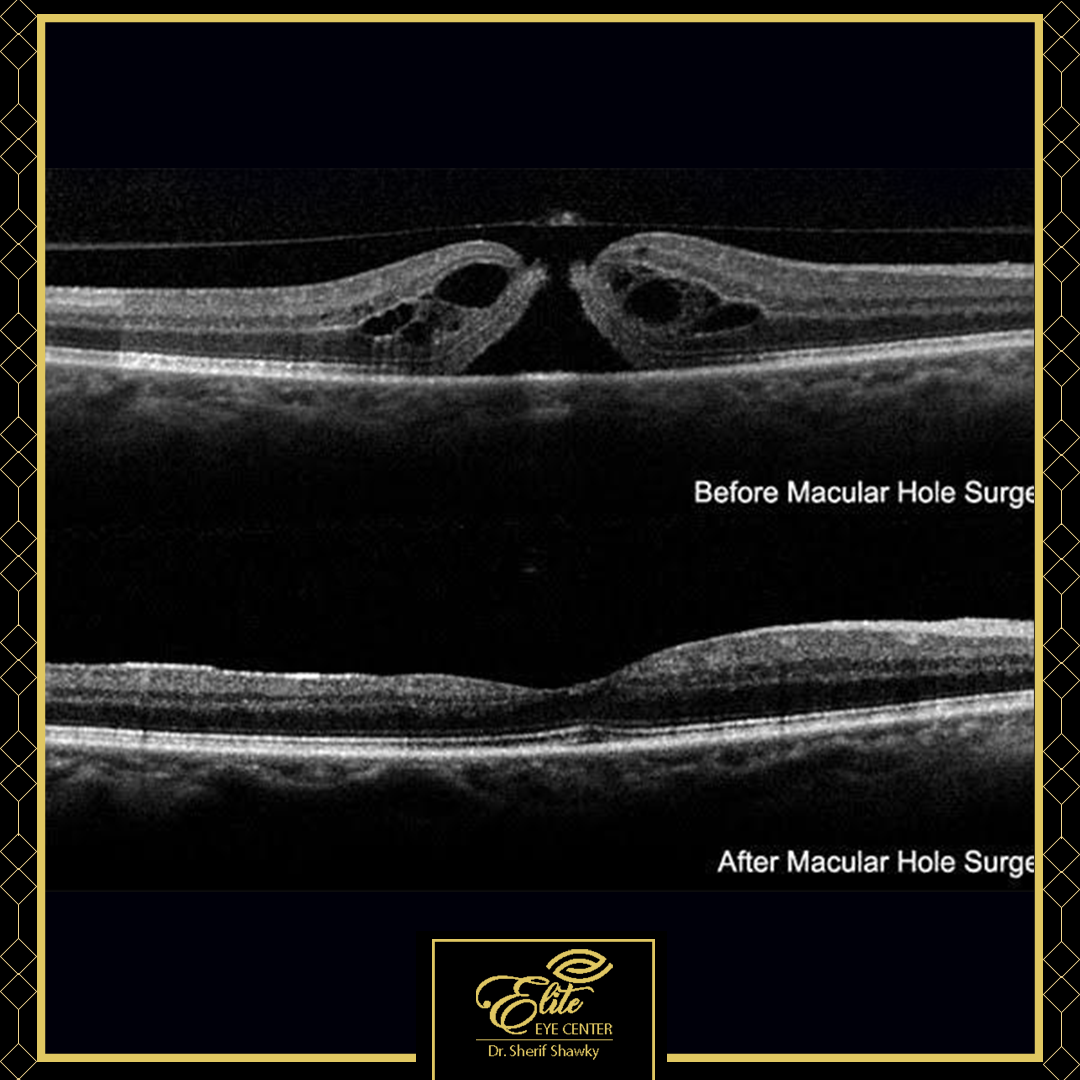
image

عن إيليت
إيليت - دكتور شريف شوقي
·درجة الدكتوراه في طب العيون
·زميل كلية الجراحين الملكية بإدنبرة (إنجلترا)
·زميل المجلس الدولي لطب العيون (كامبريدج)
·مدرس طب وجراحة العيون بكلية الطب بالقوات المسلحة (AFCM)
·زميل جامعة ولاية ميشيغان (الولايات المتحدة الأمريكية)
·عضو الجمعية المصرية لجراحة الجسم الزجاجي (EGVRS)
·عضو الجمعية الأمريكية لجراحة المياه البيضاء وتصحيح النظر (ASCRS)
·استشاري جراحة الشبكية والجسم الزجاجي
.استشاري جراحة التجميل وجراحة العيون
.استشاري جراحة المياه البيضاء وجراحة تصحيح الإبصار

الخدمات

إيليت - دكتور شريف شوقي
الليزك HD

إيليت - دكتور شريف شوقي
بروتوكول علاج ارتشاح الشبكية المزمن الغير مستجيب للعلاج

إيليت - دكتور شريف شوقي
بروتوكول علاج ارتشاح مركز الابصار المصاحب لجلطة الشبكية الوريدية

إيليت - دكتور شريف شوقي
بروتوكول علاج ارتشاح مركز الابصار لمرضي السكري

إيليت - دكتور شريف شوقي
بروتوكول علاج التغيرات السنية بالشبكية

إيليت - دكتور شريف شوقي
تصحيح ضعف النظر المرتجع بعد عمليات تصحيح الابصار

إيليت - دكتور شريف شوقي
تلميع عدسة العين بعد عمليات المياه البيضآء باستخدام الياج ليزر

إيليت - دكتور شريف شوقي
جراحات الشبكية

إيليت - دكتور شريف شوقي
جراحات العين

إيليت - دكتور شريف شوقي
زراعة عدسات IPCL لعلاج قصر النظر الشديد

إيليت - دكتور شريف شوقي
علاج ارتشاح الشبكية السكري باستخدام الأرجون ليزر

إيليت - دكتور شريف شوقي
علاج ارتشاح الشبكية باستخدام الليزر التحفيزي

إيليت - دكتور شريف شوقي
علاج اعتلال الشبكية السكري باستخدام الأرجون ليزر

إيليت - دكتور شريف شوقي
علاج الشوائب الزجاجية الكثيفة بتقنية الليزر YAG

إيليت - دكتور شريف شوقي
علاج قطع الشبكية باستخدام الأرجون ليزر

إيليت - دكتور شريف شوقي
عمليات تجميل الجفون السفلية

إيليت - دكتور شريف شوقي
عمليات تجميل الجفون العلوية

إيليت - دكتور شريف شوقي
عملية إزالة تليفات مركز الابصار

إيليت - دكتور شريف شوقي
عملية إزالة نزيف الجسم الزجاجي

إيليت - دكتور شريف شوقي
عملية تصحيح انفصال الشبكية للمرة الثانية

إيليت - دكتور شريف شوقي
عملية تصليح انفصال الشبكية
إيليت - دكتور شريف شوقي
عملية تصليح ثقب مركز أبصار

إيليت - دكتور شريف شوقي
عملية زراعة الشبكية لعلاج ثقب مركز الابصار الغير مستجيب للجراحات الأخرى

إيليت - دكتور شريف شوقي
فحص شامل للعين

إيليت - دكتور شريف شوقي
الفيمتوسمايل

إيليت - دكتور شريف شوقي
زراعات عدسات EDOF لعلاج اعتام عدسة العين

إيليت - دكتور شريف شوقي
زراعه عدسات متعددة البؤر

إيليت - دكتور شريف شوقي
الفيمتو ليزك

إيليت - دكتور شريف شوقي
بروتوكولات علاج ارتشاح مركز الابصار بالحقن الدوائي

إيليت - دكتور شريف شوقي
الليزك

إيليت - دكتور شريف شوقي
زراعة عدسات أحادية البؤر

إيليت - دكتور شريف شوقي
عمليات تصحيح الأبصار بالفيمتوليزر

إيليت - دكتور شريف شوقي
الليزك السطحي

إيليت - دكتور شريف شوقي
عمليات المياه البيضاء

إيليت - دكتور شريف شوقي
عمليات زراعة العدسات لعلاج ضعف النظر الشديد

إيليت - دكتور شريف شوقي
عمليات تجميل الجفون

إيليت - دكتور شريف شوقي
علاج الشبكية بالليزر
Our Partners





تواصل معنا
إحجز الأن
تواصل معنا
إيليت - دكتور شريف شوقي
-
للإتصال
01067994619 -
البريد الألكتروني للتواصل
info@dr-sherifshawky.com -
Cairo business plaza Mid town 90th street beside future university Mall south Floor 4 clinic 406
-
مستشفى المشرق للعيون -102 شارع السيد الميرغني مصر الجديدة - القاهرة ، مصر
-
G6 الدور السادس T2 Bussiness complex شارع الطيران أمام مستشفى التأمين الصحي و مركز مؤتمرات الأزهر مدينة نصر
